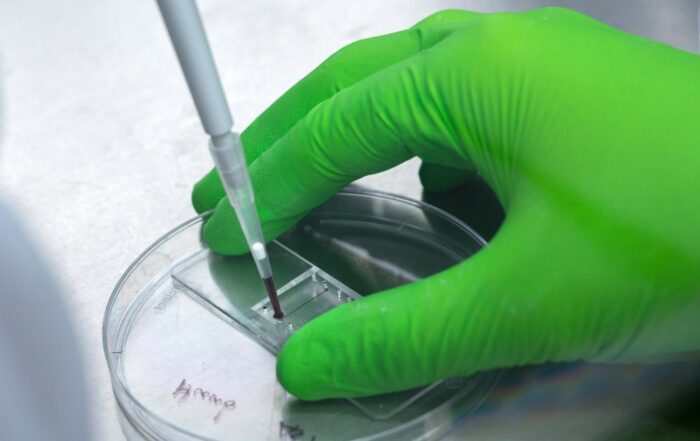

In onderstaande blogs vertellen onderzoekers wat hen motiveert om tegen de stroming in te gaan en hun onderzoek proefdiervrij te doen.
Deze onderzoekers inspireren ons, en nog belangrijker; anderen. Zij bewijzen dat de proefdiervrije wetenschap de toekomst heeft.
Groot Hertoginnelaan 201
2517 ES Den Haag
Telefoon: +31 (0)70 306 2468
E-mail: info@proefdiervrij.nl